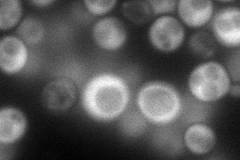
YLL013C
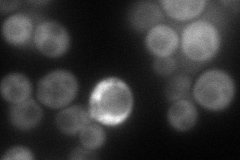
YLL013C
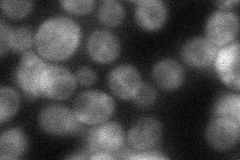
YLL013C
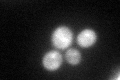
YLL013C
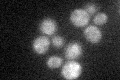
YLL013C

View description
Protein of the mitochondrial outer surface, links the Arp2/3 complex with the mitochore during anterograde mitochondrial movement; also binds to and promotes degradation of mRNAs for select nuclear-encoded mitochondrial proteins
Localization:
Intensity:
Fold change:
Significance:
-
C’ GFP library in SD

cytosol44.99 -
N' NOP1pr-GFP in SD
cytosol98.6987 -
N' TEF2pr-mCherry in SD
cytosol71.1372 -
N' NATIVEpr-GFP in SD
cytosol48.9855 -
N' TEF2pr-VC and Cyto-VN in SD

cytosol41.4161 -
C’ GFP library in SD+DTT
cytosol46.171.02No -
C’ GFP library in SD+H2O2

cytosol44.870.99No -
C’ GFP library in Starvation Media
cytosol31.970.71No -
C’ GFP library on the background of Pup2-DaMP

cytosol -
C’ GFP library on the background of CCT mutant

cytosol48.62931.08072No
